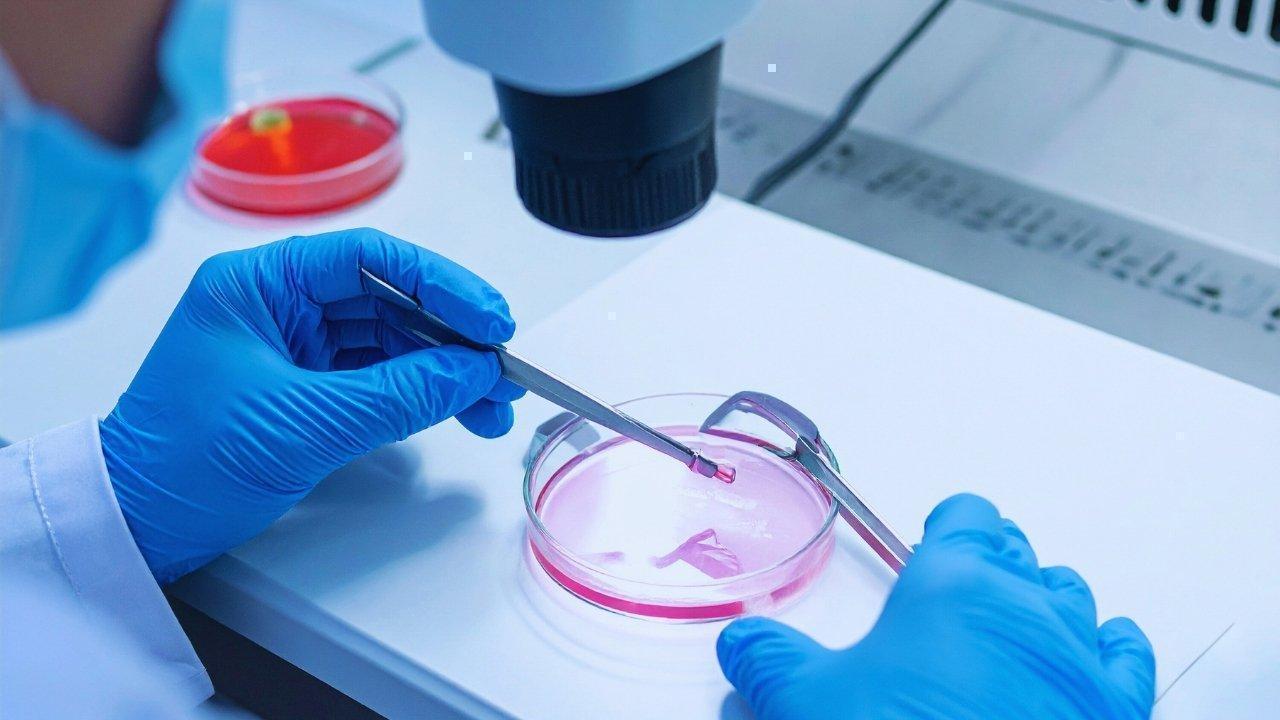

You have not yet added any article to your bookmarks!

Join 10k+ people to get notified about new posts, news and tips.
Do not worry we don't spam!

Bioplastics are emerging as sustainable alternatives to traditional plastics. However, challenges s…

As cities grow denser and underground spaces expand, traditional GPS fails to provide reliable navi…

Scientists are developing night-vision contact lenses that could allow humans to see in low-light c…
In a breakthrough that could redefine reproductive medicine, scientists have successfully created h…

Find unique, lesser-known Bali experiences beyond tourist trails — hidden temples, secret beaches, …

mRNA technology, once seen only as a tool for vaccines, is now powering a new era of medicine. From…

Regenerative tourism focuses on leaving destinations and communities better than before. Unlike tra…

Countries worldwide are revising visa policies to boost tourism, simplify travel procedures, and st…

Stablecoins are transforming digital payments, but regulatory frameworks are now reshaping how they…

As financial crimes become more sophisticated, banks are increasingly leveraging AI-powered fraud d…

Retail crypto adoption is witnessing a surprising resurgence post-bear market. From younger investo…

Traveling smart in 2025 isn’t just about finding cheap flights — it’s about optimizing every part o…

Adibah Amin Honoured at KL Tribute Event
Adibah Amin honoured in Kuala Lumpur as legacy book launches RM100,000 raised to support veteran jou

Philippines Accuses China of Poisoning Waters
Philippines alleges Chinese fishermen used cyanide in disputed South China Sea waters near Second Th

Understanding Family Living Costs in Dubai: Rent, Education & Monthly Expenses
Explore the essential living costs for families in Dubai in 2026, covering rent, school fees, and ot

Essential High-Income Skills You Can Acquire at Home
Discover how to gain valuable skills like writing and digital marketing from home to boost your inco

The Hidden Costs of Daily Breakfast Skipping: Understanding the Impact on Your Health
Explore the repercussions of skipping breakfast daily, from energy dips to mood changes, and how a s
